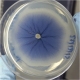

Texto pesquisado:
mente alerta
Texto pesquisado:
mente alerta
 Farmacêuticas multinacionais continuam vendendo antibióticos não aprovados na Índia
Farmacêuticas multinacionais continuam vendendo antibióticos não aprovados na Índia
 Anestesia afeta seriamente cérebro em desenvolvimento
Anestesia afeta seriamente cérebro em desenvolvimento
 Não tente segurar um espirro tapando nariz e boca
Não tente segurar um espirro tapando nariz e boca
 Como um robô descobriu que substância de dentifrício cura malária
Como um robô descobriu que substância de dentifrício cura malária
 Contra epidemia de opioides legais, processe as empresas, dizem cientistas
Contra epidemia de opioides legais, processe as empresas, dizem cientistas
 Soja e família da couve reduzem efeitos colaterais da quimioterapia
Soja e família da couve reduzem efeitos colaterais da quimioterapia
 Sistema brasileiro detecta resistência do HIV aos medicamentos
Sistema brasileiro detecta resistência do HIV aos medicamentos
 Crianças e telas: Não é só o tempo que importa
Crianças e telas: Não é só o tempo que importa
 Finalmente uma técnica para controlar a preocupação
Finalmente uma técnica para controlar a preocupação
 Trabalhadores do mundo, levantem-se
Trabalhadores do mundo, levantem-se
 Vacina contra dengue é só para quem já teve dengue
Vacina contra dengue é só para quem já teve dengue
 Folheto gratuito orienta sobre sinais de alerta do câncer infantil
Folheto gratuito orienta sobre sinais de alerta do câncer infantil
 Medicina de precisão contra câncer não é tão precisa quanto se imagina
Medicina de precisão contra câncer não é tão precisa quanto se imagina
 Aplicativo de meditação funciona - desde que incorpore a aceitação
Aplicativo de meditação funciona - desde que incorpore a aceitação
 Ioga e meditação melhoram funções cerebrais e níveis de energia
Ioga e meditação melhoram funções cerebrais e níveis de energia
 Homem com câncer de mama? O que todos devem saber
Homem com câncer de mama? O que todos devem saber
 Diferentes tipos de meditação afetam diferentes partes do cérebro
Diferentes tipos de meditação afetam diferentes partes do cérebro
 7 maneiras de domar sua mente errante e aumentar a concentração
7 maneiras de domar sua mente errante e aumentar a concentração
 Estudantes podem tirar notas melhores... acreditando que vão tirar notas melhores
Estudantes podem tirar notas melhores... acreditando que vão tirar notas melhores
 A distância que nos une - Um retrato das desigualdades brasileiras
A distância que nos une - Um retrato das desigualdades brasileiras
 Pediatras orientam creches e escolas sobre uso de medicamentos
Pediatras orientam creches e escolas sobre uso de medicamentos
 Meditação contra alcoolismo: Minutos de atenção reduzem litros de álcool
Meditação contra alcoolismo: Minutos de atenção reduzem litros de álcool
 Vírus zika está sofrendo mutações e é transmitido por meses pelo pai
Vírus zika está sofrendo mutações e é transmitido por meses pelo pai
 Pessoas que ouvem vozes têm capacidade inusitada de filtrar sons
Pessoas que ouvem vozes têm capacidade inusitada de filtrar sons
 Maratonas de seriados podem te transformar em um zumbi
Maratonas de seriados podem te transformar em um zumbi
 Imunoterapia? Esta é uma linha de pesquisa perigosa, diz cientista
Imunoterapia? Esta é uma linha de pesquisa perigosa, diz cientista
 Lutar contra as emoções negativas só piora as coisas
Lutar contra as emoções negativas só piora as coisas
 Contraste de ressonância magnética se acumula no cérebro
Contraste de ressonância magnética se acumula no cérebro
 Por que antibiótico contra conjuntivite pode ser a coisa errada a se fazer
Por que antibiótico contra conjuntivite pode ser a coisa errada a se fazer
 Entidades médicas manifestam-se contra liberação do cigarro eletrônico
Entidades médicas manifestam-se contra liberação do cigarro eletrônico
 Protetor solar de DNA protege mais quanto mais se usa
Protetor solar de DNA protege mais quanto mais se usa
 Fumo passivo na infância pode levar à artrite reumatoide
Fumo passivo na infância pode levar à artrite reumatoide
 Ministério cobra assiduidade dos médicos; CFM critica condições de trabalho
Ministério cobra assiduidade dos médicos; CFM critica condições de trabalho
 Vírus oropouche é nova ameaça de saúde pública no Brasil
Vírus oropouche é nova ameaça de saúde pública no Brasil
 Meditação e Tai Chi inibem genes da inflamação
Meditação e Tai Chi inibem genes da inflamação
 5 kg de brócolis em um comprimido controla diabetes
5 kg de brócolis em um comprimido controla diabetes
 Superbactérias avançam no Brasil; Plano de defesa continua no papel
Superbactérias avançam no Brasil; Plano de defesa continua no papel
 O que é Meditação da Mente Alerta?
O que é Meditação da Mente Alerta?
 Estatinas não protegem, aumentam o risco de Parkinson, diz novo estudo
Estatinas não protegem, aumentam o risco de Parkinson, diz novo estudo
 Melhorar a memória pode exigir novas estratégias
Melhorar a memória pode exigir novas estratégias
 Superantibiótico combate superbactérias com múltiplos poderes
Superantibiótico combate superbactérias com múltiplos poderes
 10 minutos de meditação são suficientes para reduzir ansiedade
10 minutos de meditação são suficientes para reduzir ansiedade
 Tornar-se vegetariano: Quais os riscos e as vantagens?
Tornar-se vegetariano: Quais os riscos e as vantagens?
 Descobertos na Antártica fungos contra dengue
Descobertos na Antártica fungos contra dengue
 Como detectar e lidar com risco de suicídio entre adolescentes
Como detectar e lidar com risco de suicídio entre adolescentes
 A episiotomia e os males que ela pode causar à mulher
A episiotomia e os males que ela pode causar à mulher
 Celular: Sinais indicam se você está ficando fanático ou viciado
Celular: Sinais indicam se você está ficando fanático ou viciado
 Sono profundo funciona como fonte da juventude na terceira idade
Sono profundo funciona como fonte da juventude na terceira idade
 Com depressão no topo da lista, OMS lança a campanha "Vamos conversar"
Com depressão no topo da lista, OMS lança a campanha "Vamos conversar"
 Serotonina ajuda a lidar com fortes mudanças na vida
Serotonina ajuda a lidar com fortes mudanças na vida
Mais resultados >>
Mais lidas na semana
Melhor programa de treinamento é mais simples que você imagina e dispensa academia
Sete dias de meditação reprogramam seu cérebro
Ruído rosa: Sons para dormir podem prejudicar memória e desenvolvimento cerebral
Timo saudável reduz mortalidade em até 92%
Alzheimer: Não é aglomeração de amiloides ou tau, é a competição entre elas
Basta esticar ou massagear a pele para alertar o sistema imunológico
Mais Recentes
Quer tornar sua imaginação mais vívida? Tente música ou barulho de trânsito
Obesidade prejudica ação das vacinas, mas agora há uma esperança
A natureza tem um ritmo universal para comunicação
O assunto até pode ser chato, mas a conversa vale a pena
Efeitos negativos dos adoçantes passam para próxima geração em pesquisa com animais
Conceito budista da Rede de Indra como terapia para o mundo digital
Ultrassom cria luz no interior do corpo para aplicações médicas
Emoções dos entes queridos influenciam processo de luto
Proximidade de usinas nucleares aumenta mortalidade por câncer
Terapia gênica devolve audição a pessoas que nasceram surdas
Delegar tarefas à inteligência artificial aumenta desonestidade drasticamente
Ficar ofegante poucos minutos por dia reduz risco de oito doenças
Plantão
Vacina do Butantan contra dengue grave tem 89% de proteção
Brasil tem primeiras mortes por febre oropouche no mundo
Censo 2022: Por que várias cidades brasileiras tiveram diminuição da população?
Brasil tem primeiro caso de gripe aviária em aves domésticas
Brasil decreta emergência zoossanitária devido à gripe aviária
Proibido o uso de animais em pesquisas de cosméticos e higiene pessoal
Anvisa aprova medicamento para tratamento de internados com covid-19
ANS lança campanha contra cesarianas desnecessárias
CoronaVac pode ser adaptada à variante ômicron em três meses
Anvisa libera dois produtos à base de maconha
Investir em inovação em saúde pode alavancar desenvolvimento e bem-estar
Anvisa pede que população comunique reações colaterais de vacinas
A informação disponível neste site é estritamente jornalística, não substituindo o parecer médico profissional. Sempre consulte o seu médico sobre qualquer assunto relativo à sua saúde e aos seus tratamentos e medicamentos.
Copyright 2006-2026 www.diariodasaude.com.br. Todos os direitos reservados para os respectivos detentores das marcas. Reprodução proibida.
 Os médicos devem discutir com os pais e grávidas os benefícios e os riscos de cirurgias e procedimentos que requeiram anestesia ou sedação.
Os médicos devem discutir com os pais e grávidas os benefícios e os riscos de cirurgias e procedimentos que requeiram anestesia ou sedação.  O rompimento da garganta pela contenção de um espirro é um caso inédito, mas há outros efeitos bem conhecidos e tão ou até mais graves do que esse.
O rompimento da garganta pela contenção de um espirro é um caso inédito, mas há outros efeitos bem conhecidos e tão ou até mais graves do que esse.  A descoberta foi feita por Eva, uma cientista robô que funciona com programas de inteligência artificial e comanda um laboratório automatizado.
A descoberta foi feita por Eva, uma cientista robô que funciona com programas de inteligência artificial e comanda um laboratório automatizado.  Esses alimentos induziram uma redução significativa nos efeitos colaterais da quimioterapia aplicada contra o câncer de mama.
Esses alimentos induziram uma redução significativa nos efeitos colaterais da quimioterapia aplicada contra o câncer de mama.  A técnica é capaz de detectar mutações no vírus HIV que provocam resistência ao tratamento.
A técnica é capaz de detectar mutações no vírus HIV que provocam resistência ao tratamento.  A maioria dos pais se preocupa, perguntando-se: Quanto tempo de tela é demais?
A maioria dos pais se preocupa, perguntando-se: Quanto tempo de tela é demais?
 Existem muitos conselhos e técnicas para ajudar as pessoas durante a espera, mas nenhuma vinha funcionando nos experimentos.
Existem muitos conselhos e técnicas para ajudar as pessoas durante a espera, mas nenhuma vinha funcionando nos experimentos.  Quase três quartos dos trabalhadores de escritório sabem que há uma relação negativa entre ficar sentado o dia todo no trabalho e sua saúde.
Quase três quartos dos trabalhadores de escritório sabem que há uma relação negativa entre ficar sentado o dia todo no trabalho e sua saúde.  A medicina de precisão se baseia em testes genéticos para determinar o melhor tratamento para cada paciente.
A medicina de precisão se baseia em testes genéticos para determinar o melhor tratamento para cada paciente.  A boa notícia é que alguns aplicativos de celular podem de fato ajudar os usuários a reduzir a resposta do corpo ao estresse biológico.
A boa notícia é que alguns aplicativos de celular podem de fato ajudar os usuários a reduzir a resposta do corpo ao estresse biológico.  "Há uma série de teorias sobre por que exercícios físicos como a ioga melhoram os níveis de energia e desempenho em testes cognitivos."
"Há uma série de teorias sobre por que exercícios físicos como a ioga melhoram os níveis de energia e desempenho em testes cognitivos."  Embora muito mais raro do que nas mulheres, o câncer de mama também pode surgir nos homens.
Embora muito mais raro do que nas mulheres, o câncer de mama também pode surgir nos homens.  A mensagem mais importante é que os benefícios são diferentes para cada prática.
A mensagem mais importante é que os benefícios são diferentes para cada prática.  Ficar no mundo da lua tem sido considerado o inimigo número um da concentração - mas isso nem sempre é verdade.
Ficar no mundo da lua tem sido considerado o inimigo número um da concentração - mas isso nem sempre é verdade.  Mais do que as notas anteriores, o autoconceito das próprias habilidades em cada assunto determina o sucesso posterior.
Mais do que as notas anteriores, o autoconceito das próprias habilidades em cada assunto determina o sucesso posterior.  Os seis maiores bilionários do Brasil têm a mesma riqueza e patrimônio que os 100 milhões de brasileiros mais pobres juntos.
Os seis maiores bilionários do Brasil têm a mesma riqueza e patrimônio que os 100 milhões de brasileiros mais pobres juntos.  A redução no consumo de bebidas alcoólicas foi obtida com uma sessão de treinamento de 11 minutos na técnica de meditação da atenção plena.
A redução no consumo de bebidas alcoólicas foi obtida com uma sessão de treinamento de 11 minutos na técnica de meditação da atenção plena.  Elas são capazes de usar habilidades incomuns quando seus cérebros processam novos sons.
Elas são capazes de usar habilidades incomuns quando seus cérebros processam novos sons.  Cerca de 40% dos voluntários fizeram uma maratona no mês anterior ao estudo, enquanto 28% disseram ter feito duas.
Cerca de 40% dos voluntários fizeram uma maratona no mês anterior ao estudo, enquanto 28% disseram ter feito duas.  O fracasso de um novo fármaco contra a febre chikungunya destaca a necessidade de extrema cautela ao se manipular o sistema imunológico humano.
O fracasso de um novo fármaco contra a febre chikungunya destaca a necessidade de extrema cautela ao se manipular o sistema imunológico humano.  Sentir-se mal por perceber que se está sentindo mal pode fazer com que você se sinta ainda pior.
Sentir-se mal por perceber que se está sentindo mal pode fazer com que você se sinta ainda pior.  Mais de 300 milhões de doses desses medicamentos foram administradas desde a sua introdução, em 1987.
Mais de 300 milhões de doses desses medicamentos foram administradas desde a sua introdução, em 1987.  Médicos e oftalmologistas estão emitindo um alerta de que a maioria das pessoas com conjuntivite aguda está recebendo o tratamento errado.
Médicos e oftalmologistas estão emitindo um alerta de que a maioria das pessoas com conjuntivite aguda está recebendo o tratamento errado.  A alegação é pela inexistência de comprovação científica da eficácia do cigarro eletrônico para a redução do consumo do cigarro tradicional.
A alegação é pela inexistência de comprovação científica da eficácia do cigarro eletrônico para a redução do consumo do cigarro tradicional.  Em vez de deixar o Sol danificar o DNA da pele, a ideia é acrescentar uma camada de DNA artificial para servir como "camada sacrificial".
Em vez de deixar o Sol danificar o DNA da pele, a ideia é acrescentar uma camada de DNA artificial para servir como "camada sacrificial".  O Brasil corre o sério risco de ser afligido por outro vírus de ampla distribuição nas Américas do Sul e Central e no Caribe.
O Brasil corre o sério risco de ser afligido por outro vírus de ampla distribuição nas Américas do Sul e Central e no Caribe.  A inflamação crônica está associada ao aumento do risco de condições psiquiátricos, autoimunes, cardiovasculares, neurodegenerativas e câncer.
A inflamação crônica está associada ao aumento do risco de condições psiquiátricos, autoimunes, cardiovasculares, neurodegenerativas e câncer. "Nós vimos uma redução de glicose de cerca de 10%, o que é suficiente para reduzir complicações nos olhos, rins e sangue."
"Nós vimos uma redução de glicose de cerca de 10%, o que é suficiente para reduzir complicações nos olhos, rins e sangue."  As bactérias que não respondem aos antibióticos vêm aumentando a taxas alarmantes no Brasil e já são responsáveis por ao menos 23 mil mortes anuais.
As bactérias que não respondem aos antibióticos vêm aumentando a taxas alarmantes no Brasil e já são responsáveis por ao menos 23 mil mortes anuais.  O que exatamente é a meditação baseada na atenção e por que a prática está recebendo tanta atenção da comunidade médica e científica?
O que exatamente é a meditação baseada na atenção e por que a prática está recebendo tanta atenção da comunidade médica e científica?  O uso de estatinas pode acelerar o aparecimento dos sintomas da doença de Parkinson em pessoas suscetíveis à doença.
O uso de estatinas pode acelerar o aparecimento dos sintomas da doença de Parkinson em pessoas suscetíveis à doença.  A memória não é uma entidade única, e processos de memória separados devem ser aprimorados por diferentes estados do cérebro.
A memória não é uma entidade única, e processos de memória separados devem ser aprimorados por diferentes estados do cérebro. "Os microrganismos não conseguem lidar com o trabalho de ter que encontrar três formas diferentes de combater e se livrar dos mecanismos de ação."
"Os microrganismos não conseguem lidar com o trabalho de ter que encontrar três formas diferentes de combater e se livrar dos mecanismos de ação."  Desenvolver uma consciência do momento atual reduziu incidentes de pensamento repetitivo e distração das tarefas.
Desenvolver uma consciência do momento atual reduziu incidentes de pensamento repetitivo e distração das tarefas.  Como toda mudança que envolve hábitos diários e a saúde, a opção pelo vegetarianismo deve acontecer sempre com conhecimento sobre o assunto.
Como toda mudança que envolve hábitos diários e a saúde, a opção pelo vegetarianismo deve acontecer sempre com conhecimento sobre o assunto. Fungos congelados há milênios na Antártica possuem substâncias que podem dar origem a medicamentos antivirais.
Fungos congelados há milênios na Antártica possuem substâncias que podem dar origem a medicamentos antivirais.  Especialista dá dicas de como amigos e pais podem detectar indícios de comportamento suicida e como agir nesses casos.
Especialista dá dicas de como amigos e pais podem detectar indícios de comportamento suicida e como agir nesses casos.  Baixa autoestima em relação ao próprio corpo e menos satisfação na vida sexual estão entre as consequências da episiotomia.
Baixa autoestima em relação ao próprio corpo e menos satisfação na vida sexual estão entre as consequências da episiotomia.  Os pesquisadores indicam sinais que devem servir de alerta para os usuários de celulares que estão começando a passar dos limites.
Os pesquisadores indicam sinais que devem servir de alerta para os usuários de celulares que estão começando a passar dos limites.  "Não se deixe enganar pensando que a sedação é um sono real, não é."
"Não se deixe enganar pensando que a sedação é um sono real, não é."  Segundo a entidade, mais de 300 milhões de pessoas vivem com depressão, um aumento de mais de 18% entre 2005 e 2015.
Segundo a entidade, mais de 300 milhões de pessoas vivem com depressão, um aumento de mais de 18% entre 2005 e 2015. 
